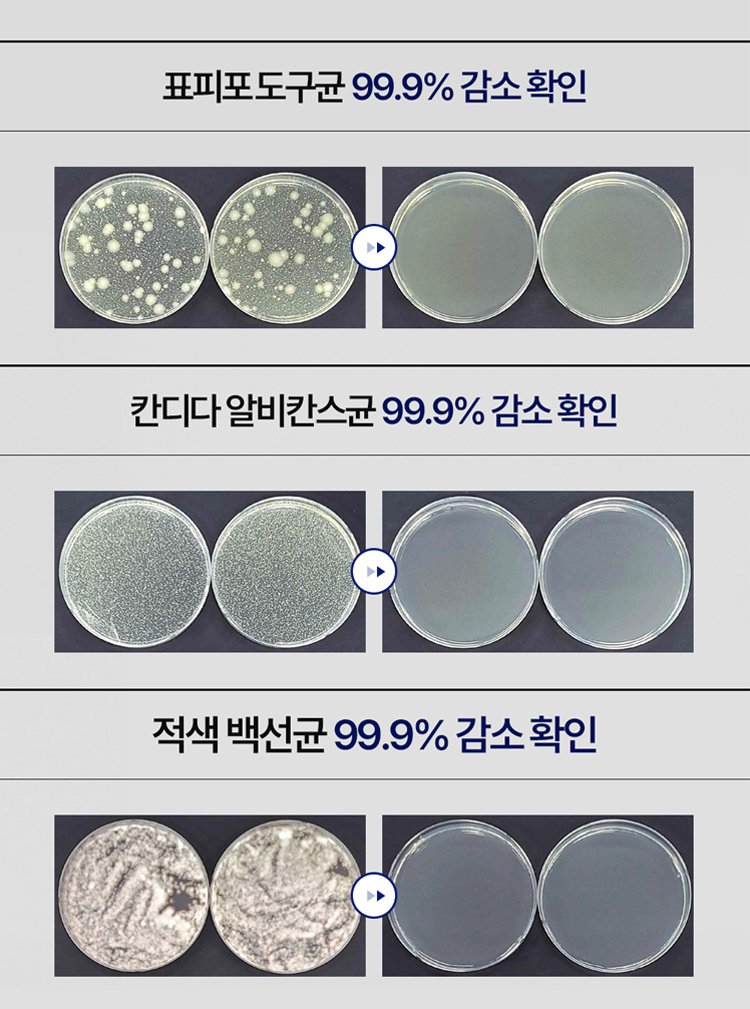

#domain# 会使用技术性 cookie 确保本网站的正常运行,而获得您的明确许可后,则会利用分析性和建档性 cookie(我方或第三方的),以便为您提供个性化的内容 和更好的浏览体验。请使用" Cookie 设置"选项,设置您的 cookie 偏好。如需深入了解 cookie 信息或修改您的 cookie 设置,请查看该 cookie 政策。点击"全部接受",则意味着您同意在自己的设备上存储所有 cookie。点击"只允许技术性 cookie"并使用"继续但不接受"按钮关闭横幅后,则意味着您明确表明: 后续将仅使用技术性 cookie并禁用其他 cookie.